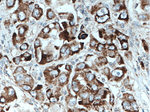
VEGF Antibody in Immunohistochemistry (Paraffin) (IHC (P))
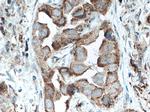
VEGF Antibody in Immunohistochemistry (Paraffin) (IHC (P))

Search
Proteintech
VEGF Polyclonal Antibody
{{$productOrderCtrl.translations['antibody.pdp.commerceCard.promotion.promotions']}}
{{$productOrderCtrl.translations['antibody.pdp.commerceCard.promotion.viewpromo']}}
{{$productOrderCtrl.translations['antibody.pdp.commerceCard.promotion.promocode']}}: {{promo.promoCode}} {{promo.promoTitle}} {{promo.promoDescription}}. {{$productOrderCtrl.translations['antibody.pdp.commerceCard.promotion.learnmore']}}

Please note: We are reviewing Western blot images included in the antibody testing data in our catalog, including those provided by third parties. Unless expressly labeled or annotated as “raw-unedited”, Western blot images included in the antibody testing data in our catalog may have been edited, optimized or otherwise adjusted for presentation.
产品信息
19003-1-AP
种属反应
已发表种属
宿主/亚型
分类
类型
抗原
偶联物
形式
浓度
规格
纯化类型
保存液
内含物
保存条件
运输条件
产品详细信息
This antibody can recognize all VEGFA isoforms.
Immunogen sequence: AAASRGQGP EPAPGGGVEG VGARGVALKL FVQLLGCSRF GGAVVRAGEA EPSGAARSAS SGREEPQPEE GEEEEEKEEE RGPQWRLGAR KPGSWTGEAA VCADSAPAAR APQALARASG RGGRVARRGA EESGPPHSPS RRGSASRAGP GRASETMNFL LSWVHWSLAL LLYLHHAKWS QAAPMAEGGG QNHHEVVKFM DVYQRSYCHP IETLVDIFQE YPDEIEYIFK PSCVPLMRCG GCCNDEGLEC VPTEESNITM QIMRIKPHQG QHIGEMSFLQ HNKCECRPKK DRARQEKCDK PRR (26-321 aa encoded by BC065522)
靶标信息
VEGF (vascular endothelial growth factor) which is a 45 kDa homodimeric, disulfide-linked glycoprotein involved in angiogenesis which promotes tumor progression and metastasis. VEGF has a variety of effects on vascular endothelium, including the ability to promote endothelial cell viability, mitogenesis, chemotaxis, and vascular permeability. The VEGF family currently includes VEGF-A, VEGF-B, VEGF-C, VEGF-D, VEGF-E, and PIGF. VEGF and its receptor system have been shown to be the fundamental regulators in the cell signaling of angiogenesis. Most tumors have the absolute requirement of angiogenesis, and VEGF has been described as the most potent angiogenic cytokine linked to this process. To date 5 different isoforms of VEGF have been described. These isoforms are generated as the result of alternative splicing from a single VEGF gene. These various isoforms have been shown to bind to two tyrosine-kinase receptors flt-1 (VEGFR-1) and flk-1/KDR (VEGFR-2), which have been found to be expressed almost exclusively on endothelial cells. VEGF and its high-affinity binding receptors, the tyrosine kinases FLK1 and FLT1, are thought to be important for the development of embryonic vasculature. Studies have shown that an alternately spliced form of FLT1 produces a soluble protein, termed sFLT1, which binds vascular endothelial growth factor with high affinity, playing an inhibitory role in angiogenesis. Elevated levels of VEGF is linked to POEMS syndrome (Polyneuropathy, Organomegaly, Endocrinopathy, Monoclonal gammopathy, Skin changes) also known as Crow-Fukase syndrome which affects multiple organs in the body.
仅用于科研。不用于诊断过程。未经明确授权不得转售。
生物信息学
蛋白别名: L-VEGF; MGC70609; RP1-261G23.1; VAS; vascular endothelial growth factor 165b; vascular endothelial growth factor A; Vascular endothelial growth factor A, long form; Vascular permeability factor; Vasculotropin; VEGF1; VEGFMGC70609; VPF; VPF ant
基因别名: VEGF; VEGFA; Vpf
UniProt ID: (Mouse) Q00731
Entrez Gene ID: (Mouse) 22339



